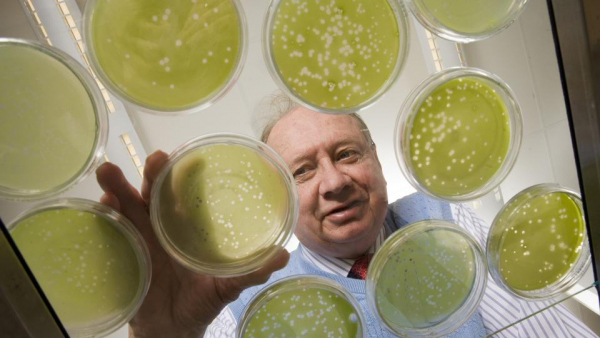
James Van Etten, coautor del estudio y profesor de Patología de las Plantas en la Universidad de Nebraska. (c) University Communications James Van Etten

Ya concluyó nuestra serie sobre la historia de la tecnología de la información y aunque resulta difícil imaginarnos su estado en las próximas dos décadas, aquí ofrecemos un breve retrato de las tendencias actuales y su futuro posible.

Ya concluyó nuestra serie sobre la historia de la tecnología de la información y aunque resulta difícil imaginarnos su estado en las próximas dos décadas, aquí ofrecemos un breve retrato de las tendencias actuales y su futuro posible.

Más de mil expertos en inteligencia artificial, científicos e investigadores de este campo firmaron una carta abierta para advertir al público general sobre la “carrera armamentista de inteligencia artificial”, y pidieron una prohibición de “armas autónomas ofensivas”.

Nuestro cuerpo contiene un sistema nervioso que funciona de forma separada de nuestro cerebro, un sistema tan complejo que ha sido llamado “el segundo cerebro”.

Un reciente hallazgo fósil nos ha permitido calcular con más precisión la cronología de la hibridación del H. sapiens con el H. neandertalensis.
Falla prueba genética
por Gina Kolata
The New York Times, Reforma, México, 9 de mayo de 2015
Prueba genética falla y genera temores
Los investigadores han temido que los científicos trataran de editar los genes humanos y terminaran alterando de forma permanente el ADN de todas las células para que cualquier cambio pase de generación a generación.
Emitieron llamados urgentes a detener ese trabajo en embriones humanos, al menos hasta que se pueda demostrar que no encierra peligros y hasta que la sociedad decida si es ético.
En marzo, científicos en China reportaron que habían intentado editar genes en embriones humanos. El experimento fracasó, precisamente de las maneras en que se había temido. Los investigadores chinos no planeaban producir un bebé -utilizaron embriones humanos defectuosos. En casi todos los casos, el embrión murió o el gen no resultó alterado. En algunos casos, el ADN del embrión sufrió una especie de daño colateral: hubo mutaciones.
Ahora les preocupa a los investigadores que los intentos continúen, con aplicaciones clínicas en mente. Temen que el resultado sea el nacimiento de bebés con todas las células alteradas por científicos apresurados para ser los primeros. Esto podría suceder mucho antes de que los investigadores sepan lo suficiente sobre las consecuencias de editar genes y cómo hacerlo sin peligro.
"El estudio (chino) debería hacer reflexionar a cualquier profesional que piense que la tecnología está lista para probarse con el fin de erradicar los genes de enfermedades durante la fertilización in vitro", dijo George Q. Daley, investigador de células madre en la Universidad de Harvard. "Éste es un procedimiento no sin riesgo y no debería practicarse en este momento, y quizá nunca".
"Esto demuestra cuán inmadura está la ciencia", afirmó David Baltimore, biólogo molecular ganador del Premio Nobel. Y agregó: "hemos aprendido mucho de sus intentos, principalmente sobre lo que puede salir mal".
La edición de genes utiliza un método llamado Crispr que se ha vuelto un elemento establecido de investigación. Explota un sistema que usan las bacterias para protegerse de los virus y permite que los investigadores retiren genes selectos e inserten nuevos.
Una pregunta apremiante, señaló Rudolf Jaenisch, profesor de biología en el Instituto Tecnológico de Massachusetts (MIT), es por qué alguien querría editar los genes de embriones humanos para prevenir las enfermedades. Incluso en los casos más severos, que involucran enfermedades como el mal de Huntingdon, en donde una sola copia de un gen mutado heredado de cualquiera de los dos padres es suficiente para causar el padecimiento con una certidumbre del 100 por ciento, la edición plantea problemas éticos.
Debido a cómo los genes están distribuidos en los embriones, cuando uno de los padres tiene el gen, sólo la mitad de sus embriones lo heredará. Con la edición de genes, cortar y pegar tiene que iniciar en un óvulo fertilizado, antes de que sea posible saber si un embrión tiene el gen de Huntingdon. Eso significa que la mitad de los embriones editados habría sido normal: su ADN sería alterado para siempre sin razón alguna. "Es inaceptable mutar embriones normales", indicó Jaenisch. "Para mí, eso significa que no hay ninguna aplicación".
Al señalar a las muchas interrogantes no contestadas sobre la edición genética de embriones humanos, un grupo de investigadores estadounidenses recientemente publicó un artículo en la revista Science que hacía un llamado a una moratoria sobre la realización de ese dicho trabajo para propósitos clínicos. Afirmaron que el conocimiento actual sobre los genes y sus interacciones es limitado y que cambiar el gen de una enfermedad en un embrión que luego se convierte en un bebé podría tener consecuencias imprevistas que serían heredadas por toda la progenie de esa persona.
Daley señala que cuando se desarrollaron las técnicas de clonación, hubo un consenso internacional de que sería inaceptable clonar a un ser humano. No obstante, algunos investigadores lo intentaron. Teme que algo similar suceda con la edición de genes.
"Este tipo de intervención recibiría aclamación mundial", expresó Daley. "Creo que ése es el tipo de motivación desquiciada que a veces insta a las personas a hacer cosas".
Miles de bebés mueren a causa de bacterias resistentes a fármacos
Por Gardiner Harris
Reforma, The New York Times, 14 de diciembre de 2014
AMRAVATI, India — Una epidemia mortal que podría tener repercusiones globales se extiende por India, y causa la muerte de decenas de miles de bebés que nacen con infecciones bacterianas resistentes a la mayoría de antibióticos conocidos.
Más de 58 mil murieron el año pasado.
Las infecciones resistentes a los antibióticos de India ya han comenzado a migrar a otras partes.
Investigadores han encontrado “superbichos” portadores de un código genético identificado primero en India —el NDM1 (o New Delhi metallo-beta lactamase 1)— en todo el mundo, incluidos países como Francia, Japón, Omán y Estados Unidos.
Autoridades de salud han advertido durante décadas que el uso excesivo de antibióticos llevaría a las bacterias a evolucionar en una forma que volviera inútiles a esos medicamentos.
India y otras naciones en desarrollo no son los únicos transgresores.
El uso excesivo de antibióticos en las granjas ganaderas de EE.UU. ha resultado en el aumento de cepas resistentes en ese país, e investigaciones han mostrado que hasta la mitad de las recetas para antibióticos en EE. UU. son innecesarias.
En EE. UU., 2 millones de personas enferman debido a bacterias resistentes todos los años y 23 mil mueren. En la Unión Europea, la cifra de muertes es similar, con 25 mil al año.
Sin embargo, los esfuerzos para reprimir el uso inapropiado de antibióticos en EE. UU. y gran parte de Europa han sido exitosos, y entre el 2000 y el 2010 disminuyó el número de recetas. Esa reducción se vio compensada, sin embargo, por su creciente uso en el mundo en desarrollo.
Las ventas globales de antibióticos para consumo humano aumentaron un 36 por ciento del 2000 al 2010, con Brasil, Rusia, India, China y Sudáfrica representando un 76 por ciento de ese incremento.
Un creciente coro de investigadores señala que ahora hay evidencia abrumadora de que una porción significativa de las bacterias presentes en India —en su agua, drenaje, animales, suelo e incluso en las madres— es inmune a casi todos los antibióticos.
Y no son solo los recién nacidos los afectados. Uppalapu Shrinivas, uno de los músicos más famosos de India, murió el 19 de septiembre a los 45 años, debido a una infección que los médicos no pudieron curar.
Los pediatras indios dicen que el creciente número de infecciones resistentes a antibióticos podría sobrepasar pronto los esfuerzos para mejorar el enorme índice de mortalidad infantil de India. Casi una tercera parte de las muertes de recién nacidos en el mundo ocurren en India. En visitas a las unidades de cuidados intensivos neonatales en cinco estados del país, los médicos dijeron sentirse abrumados.
Los recién nacidos son particularmente vulnerables debido a que sus sistemas inmunológicos son frágiles, lo que da poco tiempo a los doctores para encontrar un medicamento que funcione.
La hija de Anju Thakur, quien nació prematuramente hace un año, fue una de las víctimas de una epidemia en Amravati, una ciudad en la región central de India. Los médicos le aseguraron a la madre que aunque su hija solo pesaba un kilo 800 gramos, estaría bien. Tres días después, Thakur sabía que algo andaba mal. El estómago de su hija se infló, sus extremidades se pusieron rígidas y se le engrosó la piel —señales clásicas de una infección en la sangre—. Como precaución, los médicos le habían dado dos potentes antibióticos a la bebé poco después de nacer. Cambiaron a otros antibióticos y volvieron a cambiar. Nada funcionó. La bebé murió a los siete días de nacida.
Una prueba reveló luego que la infección era inmune a casi todos los antibióticos. La rápida muerte de la bebé significaba que la bacteria probablemente provino de su madre, dijeron los galenos.
Las bacterias se propagan con facilidad en India, dicen los expertos, porque la mitad de los indios defeca al aire libre y gran parte de las aguas residuales generadas por quienes sí usan inodoros no son tratadas. Como resultado, los indios tienen uno de los índices más altos de infecciones bacterianas en el mundo y toman, colectivamente, la mayor cantidad de antibióticos, que en el país se venden sin receta.
“En ausencia de una mejor sanidad e higiene, nos vemos forzados a depender en gran medida de los antibióticos para reducir infecciones”, dijo Ramanan Laxminarayan, vicepresidente de investigación y políticas en la Fundación de Salud Pública de India. “El resultado es que estamos perdiendo estos fármacos y nuestros recién nacidos ya enfrentan las consecuencias”.
En un estudio en curso en Delhi realizado en varios hospitales operados por el Gobierno, se encontró que casi el 70 por ciento de las infecciones de 12 mil bebés eran inmunes a múltiples antibióticos potentes.
Aunque las bacterias resistentes están en todos los lugares de India, los hospitales se han vuelto fábricas de “superbichos” intratables. Un programa del Gobierno que paga a las mujeres para que tengan a sus bebés en hospitales ha aumentado a más del doble la cantidad de niños nacidos en nosocomios en 10 años, a un 82 por ciento, pero el Gobierno hizo poco para incrementar la capacidad de los hospitales para enfrentar el aumento.
En las salas de maternidad con frecuencia hay dos o tres mujeres en cada cama, lo que permite que las infecciones se propaguen rápidamente.
Muchos hospitales son poco higiénicos, lo que permite que se desarrollen las bacterias.
A casi todos los bebés nacidos en hospitales en años recientes les inyectaron antibióticos, dijo Suresh Dalpat, subdirector de salud infantil en el estado de Haryana. “Ahora, con capacitación adecuada, estamos reduciendo eso”.
Todos los antibióticos crean bacterias resistentes que se abren paso a las aguas residuales, que en su mayoría son descargadas sin tratar en ríos, canales y pozos en la comunidad circundante, donde las mujeres embarazadas pueden infectarse.
Tras la muerte de su bebé hace un año, Thakur, de 21 años, pronto volvió a embarazarse. El 21 de septiembre dio a luz a una niña. En una visita poco después del alumbramiento, Thakur se estremecía por los escalofríos causados por una infección grave mientras se alojaba en una casa que no tenía inodoro ni agua corriente.
Casi dos meses después, reportó que ella y la bebé estaban bien.

Un estudio analítico publicado el mes pasado en la revista BioEssays concluyó que los microbios que habitan en nuestro aparato digestivo influyen, entre otras cosas, nuestras costumbres alimentarias.

Una compañía de biotecnología basada en San Francisco ha comenzado a imprimir cuernos falsos de rinoceronte en 3D para combatir la caza ilegal de este animal.
Se ha identificado un virus que normalmente infecta algas, el chlorovirus ATCV-1, en el viroma humano de la faringe.

La revista Science acaba de publicar el análisis de 17 cráneos de humanos arcaicos hallados en el yacimiento Sima de los Huesos, la pequeña cámara que se encuentra en la cueva mayor del complejo arqueológico Sierra de Atapuerca, donde se han encontrado al menos cuatro diferentes especies de homínidos.